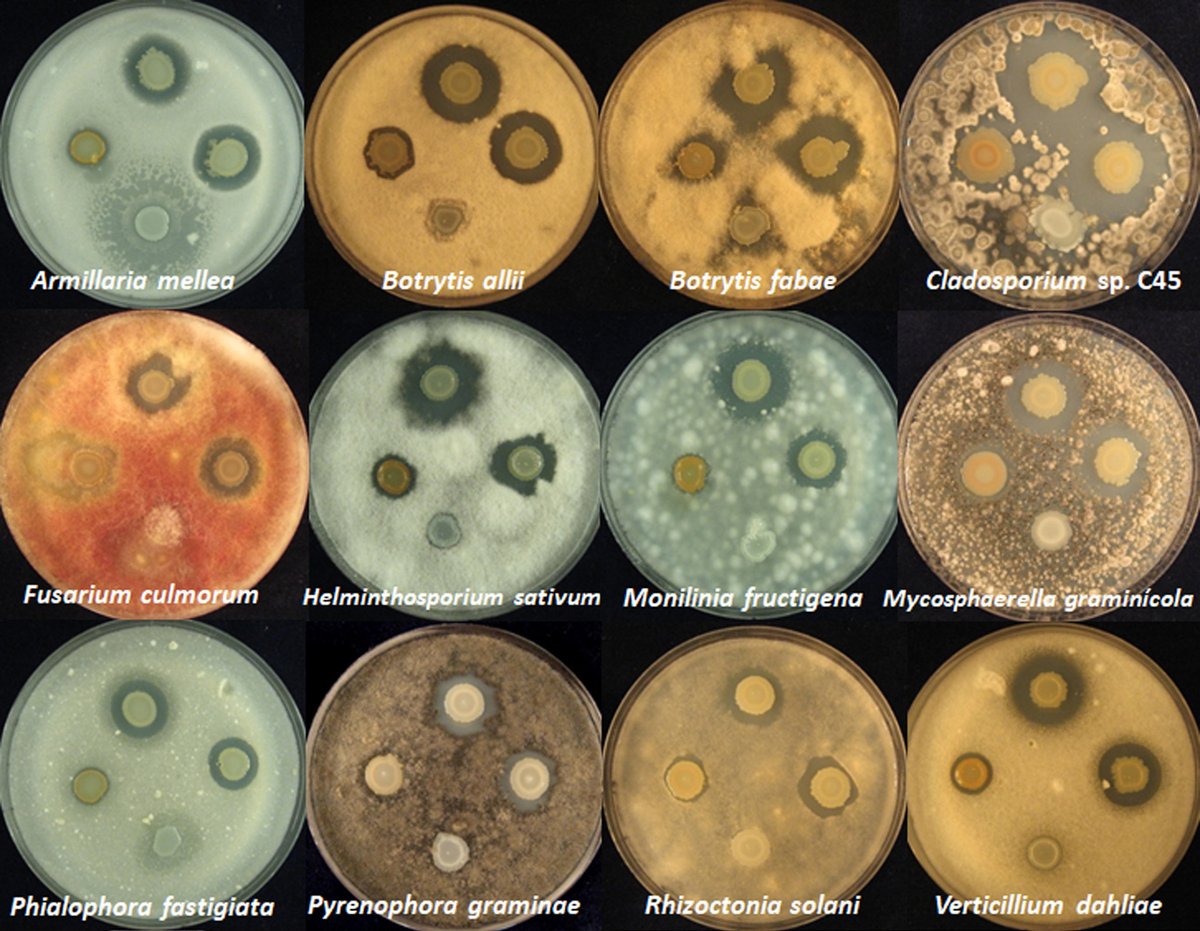
We describe in <a href="/mbiojournal/">mBio</a> the discovery of a new #antibiotic active against human and plant #pathogens. Its production is regulated by two #quorum sensing systems and enhanced under conditions that mimic the plant host. <a href="/QSPapers/">Quorum Sensing</a> <a href="/BlastMeetings/">BLAST Meetings</a> 
journals.asm.org/eprint/ZDCIXDA…

Nichith Ratheesh
@krnichu
Phd student @ASU @ASUBiodesign @bcfam_asu #microbial biophysics #biochemist #atheist #worships knowledge #where there is a will there is a way
ID: 897079689969258496
14-08-2017 12:57:19
131 Tweet
70 Followers
160 Following

Rachel_JSA College is far more easily demystified once you realize every admissions tip to applicants is a thinly veiled promise to accept students who don't exhibit signs of trauma or outside obligations that would hinder their abilities to rapaciously chase wealth upon graduation.



I am very excited today! We received the NOA for a MIRA grant from @NIGMS...very happy that the young scientists from my lab will get 5 more years to pursue their passion and creativity 🥳 ASU School of Life Sciences Biodesign Institute at Arizona State University BCFAM


A recent (official, ahem..ahem) photo of our lab. Using pipettes the 'correct' way 😀 ASU School of Life Sciences Biodesign Institute at Arizona State University


Nichith Ratheesh... I think that sums it up 😀😅🤣

We describe in mBio the discovery of a new #antibiotic active against human and plant #pathogens. Its production is regulated by two #quorum sensing systems and enhanced under conditions that mimic the plant host. Quorum Sensing BLAST Meetings journals.asm.org/eprint/ZDCIXDA…

A warm hello from the Social Media Committee Nichith Ratheesh Souvik Bhattacharyya Elizabet Monteagudo Cascales Amanda Zdimal Abhishek Shrivastava (he/him/his) Blasting off #Blastmeeting2023


A warm hello from the Social Media Committee Nichith Ratheesh Souvik Bhattacharyya Elizabet Monteagudo Cascales Amanda Zdimal Abhishek Shrivastava (he/him/his) Blasting off #Blastmeeting2023


What better than a good meal after a morning of listening to exciting science!!!! #blastmeeting2023 BLAST Meetings


#Blastmeeting2023 BLAST Meetings Next up, Nabin Bhattarai from HarsheyLab Molecular Biosciences is giving a talk on how the E. coli & Salmonella get repelled away from antibiotics and ROS using the chemoreceptor Aer.


Dr. Keith Cassidy C. Keith Cassidy is taking the stage! Exciting science talk on ‘Resolving new structural features of the E. coli chemotaxis core signaling unit’ combining molecular dynamics simulation, cryo-ET, AlphaFold2. #blastmeeting2023 @Blastmeeting



What better way to end #blastmeeting2023 than with a keynote talk by Professor Keiichi Namba on the “recent progress and future perspective of electron cryomicroscopy for structural life sciences”? BLAST Meetings #AcademicTwitter


Having a BLAST with some amazing people and peanut butter fingers on the last night of #blastmeeting2023. BLAST Meetings Amanda Zdimal Shankar Iyer





